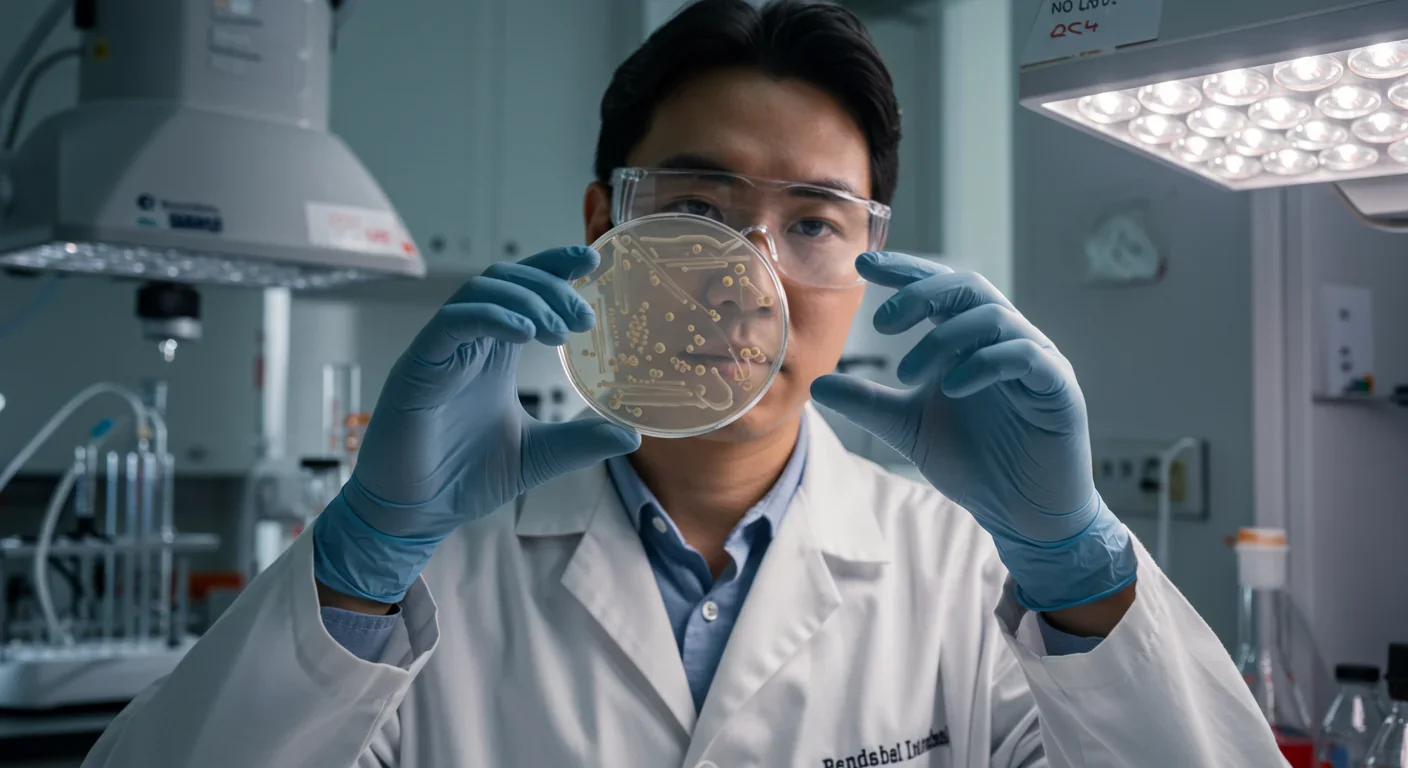
Microbiologist studying gut bacteria cultures to understand glyphosate's antimicrobial effects

How Gut Bacterium Bt Unlocks Fiber's Hidden Nutrition

TL;DR: Over 280 million pounds of glyphosate are applied annually in the U.S., with residues found in 60% of vegetables. Research shows 54% of core gut bacteria are vulnerable to this herbicide's antimicrobial effects, linking widespread exposure to rising metabolic diseases including fatty liver, diabetes, and obesity through microbiome disruption and leaky gut syndrome.
Over 280 million pounds of glyphosate are sprayed on U.S. crops every year, making it impossible to avoid. Recent research reveals that more than half of your core gut bacteria are vulnerable to this chemical's antimicrobial effects. What researchers discovered about glyphosate's impact on the microbiome connects the dots between rising herbicide use and the metabolic disease epidemic affecting millions worldwide.

When scientists at the University of Turku in Finland developed a tool to test which gut bacteria could survive glyphosate exposure, the results were startling: 54% of core human gut bacterial species are potentially sensitive to this herbicide.
Glyphosate targets an enzyme called EPSP synthase, which bacteria need to produce three essential amino acids. When this enzyme gets blocked, susceptible bacteria can't survive. Humans don't have this enzyme, which is why regulators initially considered glyphosate safe. But your gut bacteria do have it.
The bacteria most vulnerable include Lactobacillus and Bifidobacteria strains that help digest food, produce vitamins, and regulate immune function. When these beneficial species die off, harmful pathogens fill the void. It's not just theoretical. Studies show that glyphosate acts as a competitive inhibitor, binding more tightly to bacterial enzymes than their natural substrates.
You're probably consuming glyphosate right now, even if you buy organic. A 2023 study found glyphosate residues in 30% of organic food samples. Contamination happens through drift from neighboring conventional farms, shared processing equipment, and recycled fertilizers.
The herbicide shows up most frequently in grains and legumes. Oats are particularly contaminated because farmers spray them as a desiccant before harvest, speeding up drying. Testing by independent labs found glyphosate in popular oat cereals and granola bars at levels that concern toxicologists.
Water is another exposure route. Agricultural runoff carries glyphosate into streams, rivers, and groundwater. Private well testing near farming areas frequently detects the chemical, though public water systems rarely test for it.
Glyphosate-based herbicides contain surfactants that increase absorption. Research shows these formulated products allow nine times more glyphosate to penetrate skin compared to the pure chemical. Once inside, glyphosate moves quickly into bone marrow and can remain in bone tissue for extended periods, creating a slow-release reservoir.
Disrupting the microbiome is just the first domino. Glyphosate also damages the intestinal barrier itself.
Your gut lining consists of a single layer of cells held together by tight junction proteins. These junctions act like customs agents, controlling what passes from your intestines into your bloodstream. Studies indicate glyphosate weakens these tight junctions, creating gaps that allow undigested food particles, bacterial fragments, and toxins to leak through.
This condition, called intestinal hyperpermeability or leaky gut syndrome, triggers systemic inflammation as your immune system responds to these foreign invaders. The inflammation isn't localized. It circulates throughout your body, reaching organs far from your digestive tract.
Animal studies and cell culture experiments consistently demonstrate this barrier disruption. One study linked glyphosate exposure to celiac disease symptoms, noting that the herbicide damages intestinal lining in ways that mirror this autoimmune condition.
The dual impact, killing beneficial bacteria while breaking down the gut barrier, creates a perfect storm for metabolic dysfunction.
When a chemical designed to kill living organisms gets into 60% of vegetables, the question isn't whether it affects human biology. The question is how much damage we're willing to accept.
A comprehensive 2024 review of over 40 studies found that glyphosate exposure significantly raises the risk of metabolic-associated steatotic liver disease (MASLD), even at low doses.
People with higher urinary glyphosate levels had elevated fatty liver index scores. The strongest effects appeared in women aged 40-60 with borderline diabetes, a particularly vulnerable population. Cross-sectional studies showed groups with higher glyphosate exposure had greater rates of type 2 diabetes, high blood pressure, cardiovascular disease, chronic kidney disease, and obesity.
The mechanisms connecting glyphosate to metabolic disease involve multiple pathways:
Microbiome disruption alters how you extract energy from food and regulates fat storage. Certain gut bacteria produce short-chain fatty acids that influence insulin sensitivity and glucose metabolism. When glyphosate kills these bacteria, metabolic regulation falters.

Systemic inflammation from leaky gut contributes to insulin resistance. Inflammatory cytokines interfere with insulin signaling in muscle and liver tissue, forcing your pancreas to produce more insulin. Over time, this leads to pancreatic exhaustion and diabetes.
Oxidative stress triggered by glyphosate damages cellular machinery. The herbicide can impair DNA repair mechanisms and trigger oxidative damage in multiple organ systems.
The timing matters too. Research shows that children living near farms where glyphosate was applied had higher risks of developing metabolic problems later in life, suggesting early exposure programs the body for dysfunction.
Total herbicide use has increased 280% over the past three decades, with glyphosate accounting for most of that surge. The rise directly parallels the introduction of glyphosate-resistant genetically modified crops in the 1990s.
Before GMO crops, farmers used glyphosate carefully to avoid killing their plants. GMO soybeans, corn, and canola changed the equation. Farmers could spray entire fields at any growth stage without harming crops. Application rates skyrocketed.
Current estimates show over 280 million pounds applied annually in the U.S. alone, with global use far higher. The chemical now shows up in 60% of tested U.S. vegetables and appears in urine samples from people worldwide, including those with no occupational exposure.
This ubiquitous contamination creates chronic low-dose exposure that wasn't part of original safety testing. Regulators evaluated acute toxicity, not the effects of decades of daily exposure at supposedly "safe" levels.
"Glyphosate is thought to be safe because the shikimate pathway is found only in plants, fungi and bacteria. However, glyphosate may have a strong impact on bacterial species in the human microbiome, and several recent studies have shown that perturbations in the human gut microbiome are connected to many diseases."
- Docent Marjo Helander, University of Turku
The International Agency for Research on Cancer classified glyphosate as a probable human carcinogen in 2015. Yet many regulatory agencies, including the EPA, maintain the chemical is safe when used as directed.
This disconnect highlights a critical problem: regulators typically evaluate pure glyphosate, not the commercial formulations farmers actually spray. Research consistently shows glyphosate-based herbicides (GBHs) are more toxic than the active ingredient alone.

Surfactants and adjuvants in commercial formulas increase absorption, enhance tissue penetration, and may have their own toxic effects. Testing pure glyphosate misses this synergistic toxicity.
Current maximum residue limits (MRLs) vary widely between jurisdictions. The European Union has tightened restrictions and reduced approved uses, while the U.S., Canada, and Australia continue permitting widespread application. New Zealand regulators are reviewing glyphosate safety amid thousands of public objections.
The microbiome research adds another dimension regulators haven't fully addressed. If glyphosate disrupts gut bacteria at levels below current safety thresholds, those thresholds may need dramatic revision.
Not everyone faces equal risk. Certain groups experience disproportionate exposure or heightened susceptibility:
Agricultural workers and their families get exposed through occupational contact and living near treated fields. Dermal exposure matters because surfactants dramatically increase absorption through skin.
Children are particularly vulnerable. Their developing microbiomes and metabolic systems may be permanently altered by early glyphosate exposure. Studies link childhood proximity to glyphosate-treated farms with later metabolic dysfunction.
Women with borderline diabetes, especially those aged 40-60, show the strongest associations between glyphosate exposure and fatty liver disease in epidemiological studies.
People in agricultural regions with contaminated well water face constant exposure that exceeds what dietary residues alone would deliver.
Those eating conventional diets high in grains, legumes, and processed foods made from commodity crops accumulate more residues than people choosing organic alternatives.
The bone retention phenomenon means exposure accumulates over time. Research shows glyphosate binds to calcium in bone tissue and releases slowly back into circulation, creating prolonged systemic exposure long after direct contact ends.
Your purchasing decisions shape agricultural practices. Every organic purchase signals demand for farming systems that don't rely on glyphosate saturation.
Here's an ironic twist: glyphosate exposure may be making dangerous bacteria harder to kill with antibiotics.
Studies on soil bacteria show glyphosate exposure can promote antibiotic resistance. The mechanisms are still being investigated, but evidence suggests the herbicide triggers stress responses that activate genes conferring resistance to multiple drugs.
If this occurs in gut bacteria, glyphosate exposure could be contributing to the antibiotic resistance crisis while simultaneously killing beneficial species. You'd end up with a gut dominated by resistant pathogens, exactly the opposite of what you want.

Completely avoiding glyphosate is nearly impossible, but you can reduce exposure substantially:
Switch to organic for high-risk foods. Prioritize organic versions of oats, wheat, legumes, corn, and soy products. These crops receive the heaviest glyphosate applications. A study showed switching to organic diet cleared pesticide metabolites from urine within days, demonstrating your body can eliminate glyphosate when exposure stops.
Test your water. If you have a private well in an agricultural area, get it tested for glyphosate. Public water systems rarely monitor for it. Reverse osmosis and activated carbon filters can remove glyphosate from drinking water.
Choose certified products carefully. Look for certifications that test for glyphosate residues, not just organic certification. Some brands specifically test and label products as glyphosate-free.
Support your microbiome. Consuming fermented foods, prebiotics, and diverse fiber sources can help maintain beneficial bacteria populations even under environmental stress. While this doesn't eliminate glyphosate, it may buffer some of its effects.
Minimize processed foods. Glyphosate residues concentrate in products made from commodity crops like corn syrup, soy protein, and wheat flour. Whole foods offer fewer pathways for contamination.
Advocate for change. Contact representatives about tightening residue limits and requiring testing of commercial formulations, not just active ingredients. Support agricultural research into non-chemical weed management.
Glyphosate use isn't just an American issue. The herbicide is applied on six continents, with heavy use in South America, Europe, and Asia. Different regulatory approaches are emerging:
The European Union represents the strictest approach, progressively reducing approved uses and lowering maximum residue limits. Some EU member states have banned glyphosate entirely.
Latin America, particularly Argentina and Brazil, uses massive quantities on GMO soy, corn, and cotton crops. Exposure levels in agricultural communities there exceed what's seen in North America.
Australia and Canada maintain permissive policies similar to the U.S., though facing increasing public pressure for restrictions.
New Zealand is conducting a major regulatory review amid public concern, with the outcome potentially influencing Pacific region policies.
This regulatory patchwork creates trade tensions. Food produced under permissive standards may not meet import requirements for countries with stricter limits. It also creates an experiment: comparing health outcomes between populations with different exposure levels could provide valuable epidemiological data.
Despite decades of use and growing research, major questions remain unanswered:
Long-term microbiome effects: Most studies examine short-term exposure. What happens to gut ecology after 20, 30, or 40 years of low-dose exposure? How does early-life disruption affect microbiome development and long-term health?
Transgenerational effects: Some research suggests glyphosate can affect multiple generations through epigenetic mechanisms. The full scope of these effects needs investigation.
Synergistic toxicity: How do glyphosate formulations interact with other pesticides, food additives, and environmental chemicals? Real-world exposure involves chemical cocktails, not isolated compounds.
Individual variation: Why do some people develop metabolic disease while others with similar exposure remain healthy? Genetic factors, baseline microbiome composition, and other variables likely modify risk.
Reversibility: If you reduce exposure, can your microbiome recover fully? Preliminary evidence suggests improvement is possible, but we don't know if damage is completely reversible.
These uncertainties shouldn't paralyze action. The precautionary principle suggests reducing exposure to chemicals with plausible mechanisms of harm, especially when alternatives exist.
The glyphosate-microbiome connection illustrates a larger issue: industrial agriculture's chemical dependence creates hidden health costs that don't appear on price tags.
Alternatives exist. Integrated pest management, cover cropping, mechanical weed control, and crop rotation can reduce or eliminate herbicide dependence. Organic farming proves large-scale production without glyphosate is feasible, though it requires different skills and often more labor.
Technology might offer solutions too. Precision agriculture using AI-guided robots could mechanically remove weeds with minimal chemical use. New crop breeding techniques might deliver weed-competitive varieties that suppress competition naturally.
The economic equation matters. Glyphosate is cheap and effective, which is why farmers rely on it. Making alternatives competitive requires investment in research, infrastructure, and farmer education.
Consumer demand drives change faster than regulation. As awareness grows about glyphosate's impact on gut health, market pressure may accomplish what policy hasn't. Major food brands already reformulate products to avoid controversial ingredients when consumers demand it.
The microbiome science is relatively new, but the pattern is clear: glyphosate affects gut bacteria, gut bacteria affect metabolic health, and metabolic disease rates are rising in parallel with herbicide use.
You can't control agricultural policy or regulatory standards. You can control what you eat, what you buy, and how you protect your gut health. Every meal is a choice between feeding your microbiome or feeding the agrochemical industry's bottom line.
The good news? Research demonstrates that switching to organic can clear glyphosate from your system within days. Your body wants to eliminate this chemical. You just have to stop putting it in.
The rise of metabolic disease isn't inevitable. It's not purely genetic. And it's not just about calories and exercise. Environmental factors, particularly those affecting your gut microbiome, play a significant role. Glyphosate is one factor you can modify.
The scientific community continues debating glyphosate's exact role in the metabolic disease epidemic. But you don't need absolute certainty to make informed choices. When a chemical kills half your gut bacteria, disrupts your intestinal barrier, and correlates with the diseases afflicting millions, reducing exposure is rational risk management.
Your microbiome took millions of years to evolve. Glyphosate has existed for 50 years. Trust your gut, literally and figuratively, about which deserves protection.

Saturn's moon Titan may harbour liquid water beneath its frozen crust, kept from freezing by ammonia acting as a natural antifreeze. New Cassini data suggests the interior could be slush with warm water pockets rather than a global ocean, and NASA's Dragonfly mission launching in 2028 aims to investigate whether this exotic environment could support life.

Bacteroides thetaiotaomicron uses 88 specialized gene clusters and over 260 enzymes to decode and digest dietary fibers humans can't break down, converting them into essential short-chain fatty acids. When fiber runs out, it eats your gut's protective mucus instead, with cascading health consequences.

Scientists are restoring Ice Age ecological dynamics through rewilding projects like Siberia's Pleistocene Park and de-extinction efforts by Colossal Biosciences. These initiatives aim to reintroduce megafauna or their proxies to repair broken ecosystems, protect Arctic permafrost, and slow climate change.

The cheerleader effect is a proven cognitive bias where people look more attractive in groups because the brain automatically averages faces, smoothing out individual flaws. Research shows the sweet spot is 3-5 people, it works for all genders, and it has real implications for dating apps and social media strategy.

The Hawaiian bobtail squid farms bioluminescent bacteria in a specialized light organ to erase its shadow in moonlit waters. This partnership, where bacteria reshape the squid's body and communicate through quorum sensing, is teaching scientists how host-microbe relationships work and inspiring new medical and biotech applications.

Millions are leaving social media platforms driven by privacy scandals, mental health concerns, and algorithmic manipulation. While 60% relapse within a week, those who stay away report dramatically improved wellbeing, and decentralized alternatives like Bluesky are surging.

Building a reliable quantum computer requires roughly 1,000 fragile physical qubits per logical qubit due to surface code error correction overhead. New code families like LDPC and neutral-atom platforms are racing to slash that ratio, with some teams claiming it could drop to as few as 5-to-1.